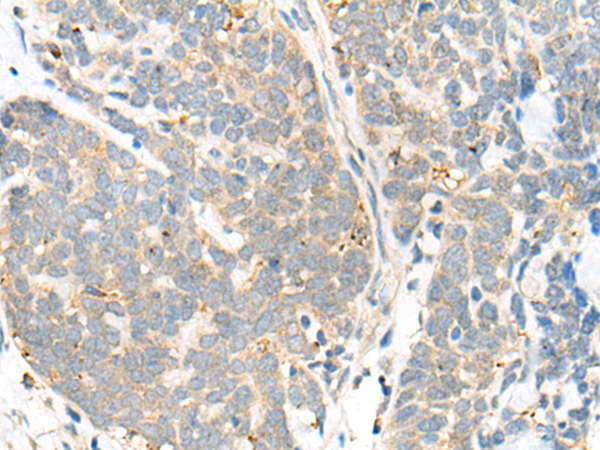

别名:CAGLP应用:IHC
反应种属:Human
规格:50μl/100μl
| Description |
|---|
| The level of intracellular calcium is tightly regulated in all eukaryotic cells. A modest increase in this level can result in a myriad of physiological responses, most of which are mediated by calmodulin (CaM), a universal calcium sensor. CaM directly modulates the activity of protein kinases and phosphatases, ion channels and nitric oxide synthetases and is generally involved in such diverse processes as cell proliferation, endocytosis, cellular adhesion, protein turnover and smooth muscle contraction. CALML6 (calmodulin-like 6), also known as CAGLP or CALGP, is a 181 amino acid protein that contains four EF-hand domains and shares functional similarity with CaM. Localized to both the nucleus and the cytoplasm, CALML6 is expressed in heart, prostate, ovary, thymus and bone marrow where it may regulate calcium-related events. |
| Specification | |
|---|---|
| Aliases | CAGLP |
| Swissprot | Q8TD86 |
| Host/Isotype | Rabbit IgG |
| Storage | Store at 4°C short term. Aliquot and store at -20°C long term. Avoid freeze/thaw cycles. |
| Species Reactivity | Human |
| Immunogen | Synthetic peptide of human CALML6 |
| Formulation | pH7.4 PBS, 0.05% NaN3, 40% Glycerol |
| Application | |
|---|---|
| IHC | 1/25-1/100 |
| ELISA | 1/5000-1/10000 |
 |
The image is immunohistochemistry of paraffin-embedded Human liver cancer tissue using P13010(CALML6 Antibody) at dilution 1/30. (Original magnification: ×200) |
|
The image is immunohistochemistry of paraffin-embedded Human thyroid cancer tissue using P13010(CALML6 Antibody) at dilution 1/30. (Original magnification: ×200) |
本公司的所有产品仅用于科学研究或者工业应用等非医疗目的,不可用于人类或动物的临床诊断或治疗,非药用,非食用。
暂无评论
本公司的所有产品仅用于科学研究或者工业应用等非医疗目的,不可用于人类或动物的临床诊断或治疗,非药用,非食用。
 中文
中文 








发表回复